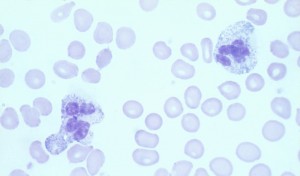

Worst diseases of the world are perhaps those which victimize children who are innocent and helpless and shouldn’t be victimized or tormented by any disease. One such disease is Kawasaki disease which attacks children and, if not treated in the early stages, can affect the heart of the child.
Conversely, if Kawasaki disease gets treated in its early days, the ill children can get back their health in a few days.
Kawasaki disease or Kawasaki Syndrome is a state in which the walls of the medium and small sized arteries in the body of the patient start suffering from inflammation. Kawasaki disease also affects the coronary arteries, the carriers of blood to the heart of the patient.
The Kawasaki Syndrome is also known as Mucocutaneous lymph-node disease since it also adversely affects the skin and the lymph nodes and mucous membranes in the throat, nose and mouth.
The symptoms of the Kawasaki disease, such as skin peeling and high fever can be very frightening but there’s favorable news that this syndrome is successfully treatable and most of the children who are the victims of Kawasaki syndrome can get rid of it without any adverse effects.
Although it is not yet known what are the possible causes of this disease; however, scientists have ruled out the possibility of this disease spreading from one patient to others through his or her touch or other ways, which means that the disease is not contagious.
Although a lot of theories exist which associate the Kawasaki disease to several viruses, bacteria and environmental reasons, not a single one has yet been proved to be the cause of Kawasaki Syndrome. However, specific genes have been pointed out by the scientists, which, if present, would make a child more susceptible to the Kawasaki disease.
